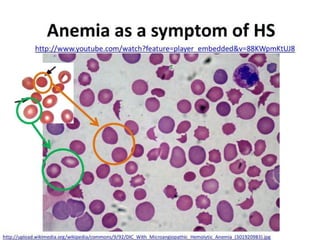

Recommended
DOC
Reporte de lectura las fuentes del curriculo
PPT
Arte hispano musulmán ii 2014
PPT
[Slideshare] tafaqqahu-(2014)-#2 c -going-to-toilet-and- clothe-(13-september...
PPT
PPT
PPT
[Slideshare] fardh'ain(august-2014-batch)#11a-(arkaan-ul-islam)-swolah-daily-...
PPT
презентация проекта Picture 1 анг версия
PPT
[Slideshare] tadzkirah-september -2014(d)-lesson-for-believers-(al-kahfi-18-5...
PPT
PPT
PDF
Konvencija o pravima deteta
PPT
24 procuring organs 1 (1)
PPT
Lenguaje visual: Imagen y comunicación
PDF
Fanding Wang Letter of Recommendation
PDF
PPT
Epoch, definitions of terrorism
PPT
23 allocating scarce resources 2 (1)
PPT
PPT
DOCX
PPT
PPT
PPT
Polygyny a woman's_viewpoint_(teresa_jan010)
PPT
Independent sample_t-test
PPT
PPT
PPT
Dispositivos de red informática
PPT
PPT
Lect 1 physical assessment
PPT
More Related Content
DOC
Reporte de lectura las fuentes del curriculo
PPT
Arte hispano musulmán ii 2014
PPT
[Slideshare] tafaqqahu-(2014)-#2 c -going-to-toilet-and- clothe-(13-september...
PPT
PPT
PPT
[Slideshare] fardh'ain(august-2014-batch)#11a-(arkaan-ul-islam)-swolah-daily-...
PPT
презентация проекта Picture 1 анг версия
PPT
[Slideshare] tadzkirah-september -2014(d)-lesson-for-believers-(al-kahfi-18-5...
What's hot
PPT
PPT
PDF
Konvencija o pravima deteta
PPT
24 procuring organs 1 (1)
PPT
Lenguaje visual: Imagen y comunicación
PDF
Fanding Wang Letter of Recommendation
PDF
PPT
Epoch, definitions of terrorism
PPT
23 allocating scarce resources 2 (1)
PPT
PPT
DOCX
PPT
PPT
PPT
Polygyny a woman's_viewpoint_(teresa_jan010)
PPT
Independent sample_t-test
PPT
PPT
PPT
Dispositivos de red informática
PPT
Similar to Hereditary spherocytosis
PPT
Lect 1 physical assessment
PPT
PPT
Wheat pill by dr sagheer part 2
PPT
PPT
Neurodevelopemental assessment-and-care-of-premature
PPT
PPT
Heparin induced thrombocytopenia dr/ Reda elsahy
PPT
смешанные дистрофии англ.
PPT
Dentist in pune.(BDS. MDS) - Dr. Amit T. Suryawanshi. Differential Diagnosis ...
PPT
PPT
PDF
PPT
PPT
PPT
Fat embolism syndrome (fes) dr. mousa
PPT
PPT
PPT
PPS
Liver cirrhosis-hematemsis-peptic Ulcer Lecture
PPT
More from αямαи мαℓιк
PPTX
Types of pediatric heart disease
PPTX
PPTX
Some basic notes on the ecg and timing
PPTX
PPTX
PPTX
Mumps, measles nd rubella
PPTX
How long does the brain stay active after death
PPTX
PPTX
PPTX
PPTX
PPTX
PPTX
Drugs for Erectile Dysfunction
PPTX
PPTX
PPTX
PPTX
PPTX
PPTX
PPTX
Plasmodium & toxoplasma
Hereditary spherocytosis 1. HH EERREEDD IITTAARRYY
SSPPHH EERROO CCYYTT OO SSIISS
((HH SS))
BBYY
nn aa ssii rr mm uu aa mm mm aa dd
ww aa ssiimm aa kk rr aa mm
aa tt ee eeqq uu ll ll aa hh
GGoo hh aa rr aa ll ii
aa zz aa zz aa ll ii
3. IInnttrroodduuccttiioonn
nHHeerreeddiittaarryy sspphheerrooccyyttoossiiss iiss aa ccllaassss ooff hheemmoollyyttiicc aanneemmiiaa..
TThhee ddiisseeaassee ooccccuurrss dduuee ttoo aann iinnttrriinnssiicc ““mmeemmbbrraannee ddeeffeecctt””
lleeaaddiinngg ttoo hheemmoollyyssiiss ooff tthhee RRBBCC’’ss..
nTThheerree aarree aa ffeeww ootthheerr aanneemmiiaass iinn tthhee ssaammee ccllaassss ooff
hheerreeddiittaarryy sspphheerrooccyyttoossiiss,, wwhhiicchh sshhaarree ssoommee ooff tthhee ssaammee
ffeeaattuurreess,, ee gg..,, bbeeiinngg hheerreeddiittaarryy,, hheemmoollyyttiicc,, aanndd ccaauusseedd bbyy
aann iinnttrriinnssiicc ddeeffeecctt..
nTThheessee ttyyppeess iinncclluuddee:: eelllliippttooccyyttoossiiss,, aanndd ssttoommaattooccyyttoossiiss..
OOnnllyy HHeerreeddiittaarryy SSpphheerrooccyyttoossiiss ((HHSS)) iiss ddiissccuusssseedd iinn ddeettaaiill iinn
tthhiiss ccoouurrssee..
5. nGGeenneerraallllyy,, aallll hheemmoollyyttiicc aanneemmiiaa iinn tthhiiss ccllaassss ooccccuurr dduuee
ttoo aa mmaajjoorr ddeeffeecctt iinn cceellll mmeemmbbrraannee iinntteeggrriittyy..
nTThhaatt iiss,, tthhee aanneemmiiaa ooccccuurrss dduuee ttoo aalltteerraattiioonnss iinn oonnee oorr
mmoorree vviittaall ssttrruuccttuurraall pprrootteeiinn((ss)) lleeaaddiinngg ttoo aann iimmbbaallaannccee
iinn tthhee mmeemmbbrraannee lliippiidd ccoonntteenntt aanndd ccaattiioonn ttrraannssppoorrtt..
nSSeeqquueennttiiaallllyy,, ssuucchh aalltteerraattiioonnss lleeaadd ttoo tthhee lloossss ooff cceellll
ssuurrffaaccee aarreeaa,, iinnccrreeaasseedd rriiggiiddiittyy,, ffrraaggmmeennttaattiioonn,, aanndd
tthheerreeffoorree,, iinnccrreeaasseedd ffrraaggiilliittyy ttoo sspplleenniicc
sseeqquueessttrraattiioonn..
nIInn ootthheerr wwoorrddss,, dduuee ttoo tthhee aabbnnoorrmmaall cceellll mmeemmbbrraannee,,
tthhee cceellllss ggeett ttrraappppeedd iinn tthhee sspplleeeenn’’ss mmiiccrroocciirrccuullaattiioonn
aanndd ggeett ddeessttrrooyyeedd pprreemmaattuurreellyy ((bbeeffoorree tthhee 112200 ddaayyss
lliiffee ssppaann))..
7. PPaa tt hh oo pp hh yy ssii oo ll oo gg yy
nTThhee aanneemmiiaa iiss ggeenneettiiccaallllyy ppaasssseedd ddoowwnn ffrroomm oonnee
ggeenneerraattiioonn ttoo aannootthheerr..
nTThhee ddiisseeaassee iiss tthhee mmoosstt ccoommmmoonn hheemmoollyyttiicc aanneemmiiaa
eennccoouunntteerreedd iinn nnoorrtthheerrnn EEuurrooppee,, uussuuaallllyy aaffffeeccttiinngg
mmoorree tthhaann oonnee mmeemmbbeerr iinn tthhee ssaammee ffaammiillyy..
nTThhee bbaassiicc ddeeffeecctt iinn HHSS iiss aa mmeemmbbrraannee aabbnnoorrmmaalliittyy
ccaauusseedd bbyy ddyyssffuunnccttiioonnaall aanndd// oorr ddeeffiicciieenncciieess iinn oonnee oorr
mmoorree ooff tthhee ffoolllloowwiinnggss:: SSppeeccttrriinn,, AAnnkkyyrriinn,, BBaanndd 33,, aanndd
PPrrootteeiinn 44..22,, aallll ooff wwhhiicchh aarree vviittaall ccoommppoonneennttss
((ssttrruuccttuurraall pprrootteeiinnss)) ooff tthhee cceellll mmeemmbbrraannee..
8. SSppeecciiffiiccaallllyy,, tthheessee lleeaadd ttoo::
nDDeeccrreeaasseedd lliippiidd ccoonntteenntt
nRReedduucceedd cceellll ssuurrffaaccee aarreeaa
nIImmppaaiirreedd fflleexxiibbiilliittyy,, aanndd
nIInnccrreeaasseedd ppeerrmmeeaabbiilliittyy ttoo ssooddiiuumm,, wwhhiicchh tthhee
cceellllss ppuummpp oouutt ttoo ssttaabbiilliizzee tthhee oossmmoottiicc ffrraaggiilliittyy..
SSuucchh pprroocceessss rreeqquuiirreess aa lloott ooff AATTPP
ccoonnssuummppttiioonn..
9. nDDeessppiittee aallll ooff tthhaatt,, tthhee cceellllss lliiffee ssppaann rreemmaaiinnss
uunnaaffffeecctteedd uunnttiill tthhee cceellllss rreeaacchh tthhee sspplleeeenn,,
wwhheerree gglluuccoossee aanndd AATTPP lleevveellss aarree iinnssuuffffiicciieenntt..
TThheerreeffoorree,, tthhee cceellllss ccaannnnoott ppuummpp oouutt tthhee eexxttrraa
ssooddiiuumm lleeaaddiinngg ttoo aann iinnccrreeaasseedd iinnttrraacceelllluullaarr
ssooddiiuumm ccoonncceennttrraattiioonnss aanndd ssuubbsseeqquueennttllyy,,
iinnccrreeaasseedd wwaatteerr ccoonntteenntt.. TThhiiss lleeaaddss ttoo tthhee
sswweelllliinngg aanndd rriiggiiddiittyy ooff tthhee cceellllss wwhhiicchh ccaannnnoott
nneeggoottiiaattee tthhee sspplleeeenn’’ss mmiiccrroocciirrccuullaattiioonn wwhheerree
tthheeyy ggeett ttrraappppeedd aanndd pphhaaggooccyyttoozzeedd..
10. LLaabb ffiinnddiinnggss
nAAss tthhee nnaammee iinnddiiccaatteess,, tthhee cchhaarraacctteerriissttiicc ffeeaattuurree ooff
tthhiiss aanneemmiiaa iiss tthhee pprreesseennccee ooff mmiiccrrooccyyttiicc sspphheerrooccyytteess
iinn ppeerriipphheerraall bblloooodd..
nMMiilldd aanneemmiiaa wwiitthh hheemmoogglloobbiinn ccoonncceennttrraattiioonnss ooff
aabboovvee 1100 gg//ddLL..
nMMCCVV iiss uussuuaallllyy wwiitthhiinn nnoorrmmaall rraannggee bbuutt ggeettss
iinnccrreeaasseedd oorr ddeeccrreeaasseedd ddeeppeennddiinngg oonn tthhee nnuummbbeerr ooff
rreettiiccuullooccyytteess pprreesseenntt..
nMMCCHHCC iiss uussuuaallllyy iinnccrreeaasseedd iinn aa llaarrggee ppoorrttiioonn ooff
ppaattiieennttss.. HHSS iiss tthhee oonnllyy aanneemmiiaa tthhaatt ccaann hhaavvee MMCCHHCC
vvaalluueess aabboovvee nnoorrmmaall rraannggee..
nRReettiiccuullooccyytteess aarree uussuuaallllyy iinnccrreeaasseedd bbeettwweeeenn 55 aanndd
2200%% wwiitthh hhiigghheerr ccoouunnttss sseeeenn iinn ppaattiieennttss rreeccoovveerriinngg..
11. CCBBCC
nTThhee ppeerriipphheerraall bblloooodd ssmmeeaarr sshhoowwss cchhaarraacctteerriissttiicc
mmiiccrroo sspphheerrooccyytteess,, wwhhiicchh aappppeeaarr ssmmaallll,, ddaarrkk,, vveerryy
rroouunndd wwiitthh nnoo cceennttrraall ppaalllloorr..
12. nTThheerree ccoouulldd bbee aa mmaarrkkeedd
ddeeggrreeee ooff aanniissooccyyttoossiiss dduuee ttoo
tthhee mmiixxttuurree ooff sspphheerrooccyytteess
aanndd rreettiiccuullooccyytteess
((ppoollyycchhrroommaattoopphhiilliiaa))..
nOOtthheerr ppooiikkiillooccyyttoossiiss ((ootthheerr
tthhaann sspphheerrooccyytteess)) aarree nnoott
uussuuaallllyy sseeeenn,, uunnlleessss iinn tthhee
vveerryy sseevveerree ffoorrmmss ooff tthhee
ddiisseeaassee..
13. BBoonnee MMaarrrrooww
nDDuurriinngg tthhee eeaarrllyy ssttaaggeess,, tthhee BBMM sshhoowwss
eerryytthhrrooiidd hhyyppeerrppllaassiiaa,, wwhhiicchh cchhaannggeess ttoo
hhyyppooppllaassiiaa dduurriinngg ““AAppllaassttiicc CCrriissiiss
((RReettiiccuullooccyyttooppeenniiaa))””..
14. nAAddddiittiioonnaall ttoo tthhee cchhaarraacctteerriissttiicc mmoorrpphhoollooggyy ooff
sspphheerrooccyytteess iinn ppbb,, tthhee ““OOssmmoottiicc FFrraaggiilliittyy””tteesstt
iiss ccoonnssiiddeerreedd aass tthhee ddiiaaggnnoossttiicc llaabb tteesstt ttoo bbee
ppeerrffoorrmmeedd..
nOOtthheerr uusseeffuull tteessttss iinn ddiiaaggnnoossiiss iinncclluuddee tthhee
aauuttoohhaaeemmoollyyssiiss tteesstt,, aanndd tthhee ddiirreecctt aannttiigglloobbuulliinn
tteesstt""wwhhiicchh wwiillll bbee nneeggaattiivvee"" ..
AAdd dd iitt ii oo nn aa ll LLaa bb DD iiaa gg nn oo ssiiss
15. 16.